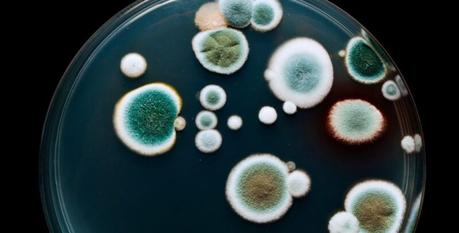
The Earth’s Gift: Understanding the Health Benefits of Water Stored in Clay Pots The Earth's Gift: Understanding the Health Benefits of Water Stored in Clay Pots

wellhealthorganic.com:some-amazing-health-benefits-of-drinking-water-from-an-earthen-pot: Water is essential for life, and its quality plays a significant role in maintaining good health. While modern water purification methods have advanced over time, there is a growing interest in traditional storage practices, particularly the use of clay pots. Clay pots have been used for centuries to store and cool water in many cultures worldwide.
This article aims to explore the health benefits associated with water stored in clay pots, shedding light on the scientific basis behind these age-old practices. By understanding the properties of clay and its interaction with water, we can gain insights into the potential advantages of using clay pots as a natural means of enhancing water quality and promoting overall well-being.
The Science of Clay

Clay is a natural material composed of finely grained minerals, such as silicates, oxides, and organic matter. It has unique properties that make it a suitable medium for water storage. Clay is porous, allowing water to pass through its microscopic channels. This porosity enables the clay to absorb impurities, such as suspended particles, bacteria, and certain chemicals, thereby acting as a natural filter.
Additionally, clay has a high cation exchange capacity (CEC). CEC refers to the ability of clay particles to attract and hold positively charged ions, such as calcium, magnesium, and potassium. As water comes into contact with clay, these beneficial minerals are released into the water, enriching its composition. The presence of these minerals can contribute to improved taste and potential health benefits.
Cooling and Alkalinity

One of the remarkable properties of clay pots is their cooling effect on stored water. Clay is a porous material, allowing a small amount of water to evaporate through its walls. This evaporation process leads to a cooling effect, making the water stored in clay pots pleasantly cool, even in hot climates. This natural cooling mechanism is often preferred over refrigeration methods, as it does not require electricity.
Another noteworthy aspect of water stored in clay pots is its alkaline nature. Clay has a slightly alkaline pH, typically ranging from 7.2 to 8.5. When water comes into contact with clay, it undergoes a gradual ion exchange process, resulting in a rise in pH. Alkaline water has gained attention due to its potential health benefits, including antioxidant properties and the ability to neutralize excess acidity in the body. While further research is needed, the alkaline nature of water stored in clay pots may offer additional advantages for human health.
Reduction of Microbial Contaminants
Waterborne diseases caused by microbial contaminants are a major concern, particularly in regions with limited access to clean water. Clay pots have been traditionally used for their ability to inhibit the growth of harmful bacteria. Research suggests that clay possesses antimicrobial properties, which may help reduce the presence of pathogens in stored water.
Studies have demonstrated that clay exhibits antibacterial activity against various pathogens, including Escherichia coli and Salmonella species. The mechanism behind this antimicrobial effect is attributed to several factors, such as the physical trapping of bacteria within the porous structure of clay, the release of antimicrobial ions from the clay particles, and the production of metabolites by clay-associated microorganisms.
Furthermore, clay pots’ porous nature and the evaporation process contribute to the reduction of microbial contaminants. As water evaporates through the walls of the pot, any microorganisms present in the water are left behind, effectively reducing their concentration. This natural purification process, combined with the antimicrobial properties of clay, can potentially enhance the safety of stored water.
Conclusion
Water stored in clay pots offers a range of potential health benefits. The porous nature of clay allows for natural filtration, reducing impurities and improving water quality. The cooling effect of clay pots provides refreshing drinking water, particularly in hot climates, without the need for electricity. Moreover, the alkaline pH of water stored in clay pots may offer additional advantages, although more research is required in this area.
Furthermore, the antimicrobial properties of clay contribute to the reduction of microbial contaminants, potentially enhancing the safety of stored water. However, it is important to note that clay pots alone may not be sufficient to completely purify contaminated water, and regular cleaning and maintenance of the pots are necessary.
In conclusion, the age-old practice of storing water in clay pots holds scientific merit. By harnessing the properties of clay, we can appreciate the potential health benefits associated with this traditional method. Incorporating clay pots into our modern water storage practices may offer a natural and sustainable approach to improving water quality and promoting overall well-being.
The post The Earth’s Gift: Understanding the Health Benefits of Water Stored in Clay Pots first appeared on .
